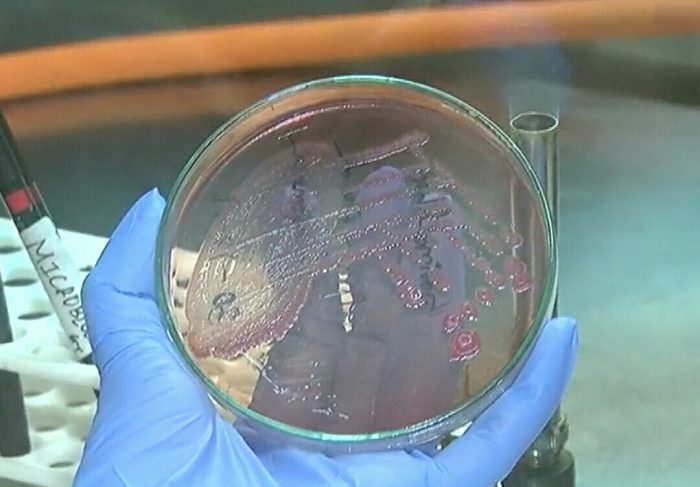

ગુજરાતમાં પહેલી વાર સુરતની વિનસ હોસ્પિટલમાં મિલિઓઇડોસિસ નામના રોગના બેક્ટેરિયા એક દર્દીના પરુમાંથી શોધી કાઢવામાં આવ્યા છે.

નવસારીના 58 વર્ષના નિવૃત્ત શિક્ષક છેલ્લા બે મહિનાથી ઉધરસ, તાવ, ભૂખ ન લાગવી અને વજનમાં ઘટાડો થવો જેવી સમસ્યાથી પીડાતા હતા. જેથી તેમણે સુરતની વિનસ હોસ્પિટલમાં સારવાર લેવાનું નક્કી કર્યું. જોકે, સારવાર દરમિયાન હોસ્પિટલના ફિઝિશિયન ડો.નિખિલ જરીવાલાને ફેફસાંમાં પરુ જણાતાં પરુ કાઢી હોસ્પિટલની લેબમાં મોકલવામાં આવ્યું અને તપાસ કરવામાં આવતાં માઇક્રોબાયોલોજિસ્ટ ડો.ફેનિલ મુનીમે મિલિઓઇડોસિસ રોગના બેક્ટેરિયા હોવાનું શોધી કાઢ્યું હતું.

હોસ્પિટલ દ્વારા તરત જ જિલ્લા એપિડેમિક ઓફિસરને જાણ કરવામાં આવી હતી અને પરુની તપાસ સરકારી લેબમાં કરી ખાતરી કરવામાં આવતાં વાત સાચી સાબિત થઈ હતી અને ત્યાર બાદ સેન્ટર ફોર ઇમેજિંગ એન્ડ ટ્રોપિકલ ડિસીઝ, કર્ણાટક ખાતે પણ તપાસ માટે સેમ્પલ મોકલવામાં આવતાં મિલિઓઇડોસિસ રોગના જ બેક્ટેરિયા હોવાનું ફલિત થયું હતું. સેન્ટર ફોર ઇમેજિંગ એન્ડ ટ્રોપિકલ ડિસીઝના ડોક્ટર ચિરંજય મુખોપાધ્યાયે પણ જણાવ્યું હતું કે, ગુજરાત રાજ્યમાં નોંધાયેલો આ પહેલો કેસ છે. મુખ્યત્વે ડાંગરની ખેતીના પાણીમાં આ બેક્ટેરિયા જોવા મળે છે.બેક્ટેરિયા શોધી કાઢનાર ડો.ફેનિલ મુનીમના જણાવ્યા અનુસાર ક્રોનિક અને એક્યુટ આ બે બેક્ટેરિયા જીવલેણ છે.હાલના દર્દીને ક્રોનિક છે. જેથી ઈલાજ ચાલી રહ્યો છે. દર્દીને સમયસર ઈલાજ ન મળે તો મૃત્યુ થઈ શકે છે.ચોખાના ખેતરમાં ખુલ્લા પગે પાણીમાં કામ કરવાથી બેક્ટેરિયા શરીરમાં પ્રવેશી જાય છે.આજ સુધી ગુજરાતમાં આ બેક્ટેરિયા નોંધાયા ન હતા.આ બેક્ટેરિયાને ડિટેક્ટ કરવા અઘરા હોય છે. જોકે,આ બેક્ટેરિયા હોવાનું અમે શોધી કાઢ્યું છે. ભારતમાં અત્યાર સુધીમાં મિલિઓઇડોસિસ રોગના માત્ર 585 કેસ નોંધાયા છે. જેમાં 306 કર્ણાટક અને 146 તામિલનાડુમાં છે.હવે ગુજરાતમાં પણ 1 કેસ નોંધાયો છે. વિયેતનામ ,ઉત્તર પૂર્વીય થાઈલેન્ડ અને દક્ષિણ એશિયાના દેશોમાં જોવા મળતાે આ રોગનાં લક્ષણોમાં વજન ઘટવું, છાતીમાં દુખાવો,તાવ, સ્નાયુઓનો દુખાવો અને ખાંસી આવવી હોય છે.બે તબક્કામાં ઈલાજ, બે એન્ટિબાયોટિક્સ મહત્વની આ રોગની સારવારમાં બે અલગ અલગ તબક્કા છે. પ્રથમ તબક્કામાં ઉપચાર અને બીજા તબક્કામાં નાબૂદ થેરાપી છે. પ્રારંભિક ઉપચારને ઇન્ટ્રાવેનસ ઉપચાર તરીકે પણ ઓળખાય છે, કારણ કે સારવારમાં દવા અને સિફ્ટાઝિડાઇમ સામેલ છે. ઉપચારનો બીજો તબક્કો નાબૂદીનો છે. જે 3 થી 6 માસ સુધી ચાલુ રાખવો જોઈએ. સારવાર માટે મુખ્યત્વે 2 એન્ટિબાયોટિક્સ છે.

સુરતની વિનસ હોસ્પિટલમાં મિલિઓઇડોસિસ નામના રોગના બેકટેરિયા એક દર્દીના પરુમાંથી શોધી કાઢવામાં આવ્યા.
Advertisement